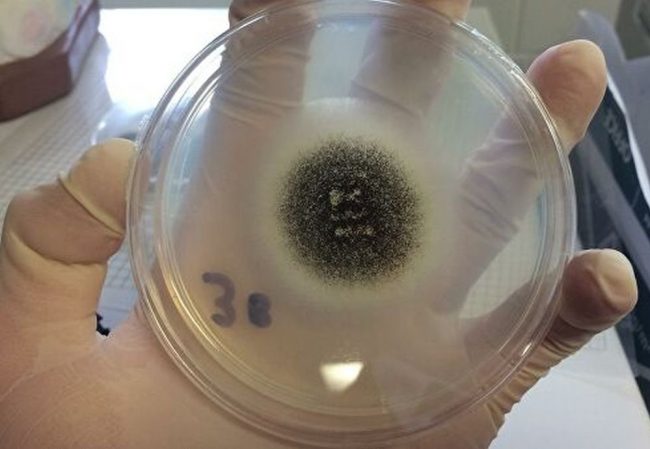

Daily Mail: посторонний запах в носу может возникать из-за опухоли в мозге
Посторонние запахи в носу могут быть вызваны длительным воспалением или инфекцией, а также полипами и опухолями мозга. Об этом рассказала британский терапевт Элли Кэннон. Врач объяснила, что потеря обоняния или изменения в его работе могут быть следствием перенесенного COVID-19 и других простудных заболеваний. Чаще всего люди ощущают, что в носу «застревают» запахи химических веществ, испорченной…